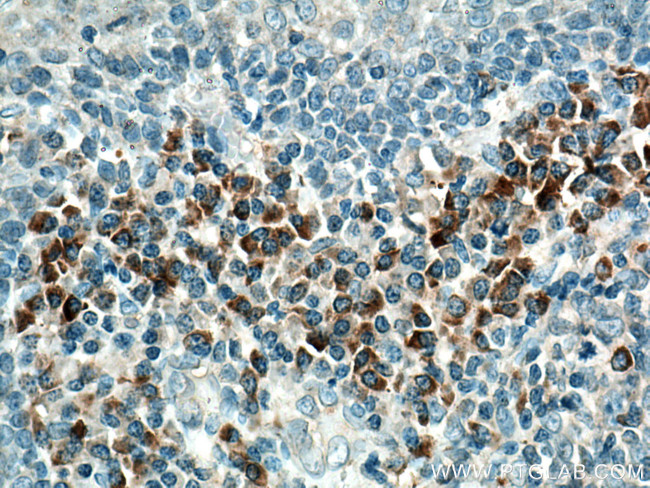
IL-23R Antibody in Immunohistochemistry (Paraffin) (IHC (P))

Search
Proteintech
IL-23R Polyclonal Antibody
{{$productOrderCtrl.translations['antibody.pdp.commerceCard.promotion.promotions']}}
{{$productOrderCtrl.translations['antibody.pdp.commerceCard.promotion.viewpromo']}}
{{$productOrderCtrl.translations['antibody.pdp.commerceCard.promotion.promocode']}}: {{promo.promoCode}} {{promo.promoTitle}} {{promo.promoDescription}}. {{$productOrderCtrl.translations['antibody.pdp.commerceCard.promotion.learnmore']}}
产品信息
27163-1-AP
种属反应
宿主/亚型
分类
类型
抗原
偶联物
形式
浓度
规格
纯化类型
保存液
内含物
保存条件
运输条件
产品详细信息
Aliquoting is unnecessary for -20°C storage.
靶标信息
IL-23R is a 629 aa, novel subunit of the receptor for cytokine IL23A/IL23 which pairs with the receptor molecule IL12RB1/IL12R beta 1and thus take part in IL23A signaling. Signal transduction analysis confirms that this protein associates constitutively with Janus kinase 2 (JAK2), and also binds to transcription activator STAT3 in a ligand-dependent manner. Alternative splicing results in six spliced isoforms of IL-23R. Reports suggest that IL-23R plays an important role in psoriasis pathogenesis and is also a potential therapeutic target in inflammatory bowel disease.
仅用于科研。不用于诊断过程。未经明确授权不得转售。
生物信息学
蛋白别名: hemopoietic cytokine receptor; IBD17; IL 23R; IL-23 receptor; IL-23R endodomain protein; IL-23R3-F3; IL-23R soluble receptor; IL-23R2-F1; IL-23R soluble receptor; IL-23R3-F1; IL-23R soluble receptor; IL-23R4; IL-23R truncated endodomain protein; IL-23R2-F2; Interleukin-23 receptor; type I cytokine receptor; IL-23R1
基因别名: IL-23R; IL23R; PSORS7
UniProt ID: (Human) Q5VWK5, (Mouse) Q8K4B4
Entrez Gene ID: (Human) 149233, (Mouse) 209590